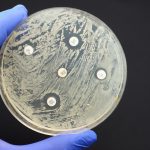
Antibiotic sensitivity test done in a petri dish.

Dr. Frank Schweizer News Archive
Rady Faculty of Health Sciences
Rady Faculty profs named to global list of highly cited researchers
February 3, 2022 —
Six Rady Faculty of Health Sciences professors have been named to the Highly Cited Researchers 2021 list.






